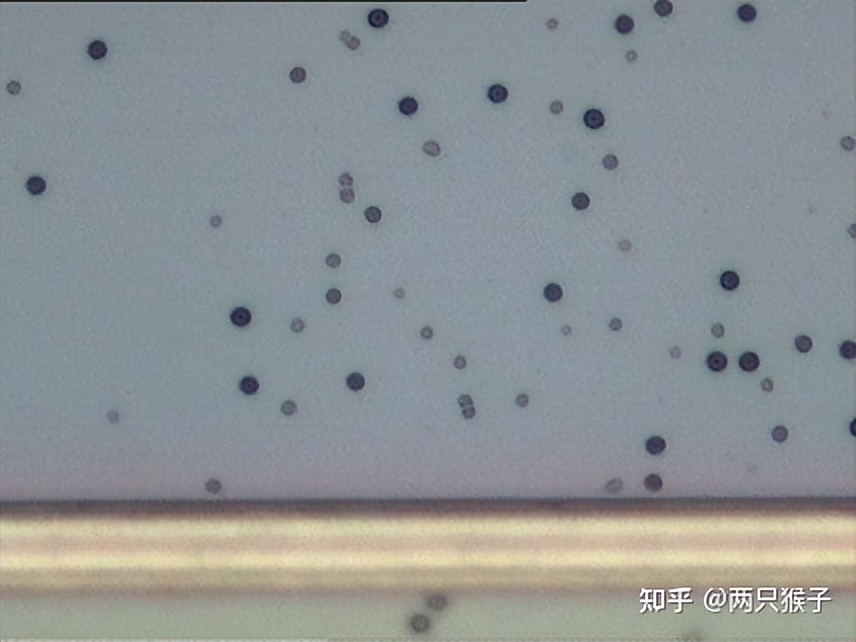
半导体Defect介绍,半导体fab优劣势

Arcing-电弧放电
外观 :金属表面呈烧焦及熔岩状,而且沿着金属线路熔毁。或圆形爆炸状
成因 :在电浆(Plasma)环境中,高浓度的带正电离子经由电弧(ARC)对晶片表面容易蓄积电荷或导电部位放电时所产生的高热熔毁金属线路。


Blind Contact / Blind VIA 介层瞎窗
外观 : Contact(连接M1/Poly) / VIA (连接M1/M2)的大小变小或完全消失不见。
成因 :
a、Photo焦距偏差(defocus),以至于contact /VIA部位曝光不足,而无法曝开;
b、Photo 光阻涂布不良,使底层被蚀刻掉。


bridge 桥接
外观 : 图形桥接
成因 : PHOTO defocus


Tape residue 残胶
外观 :胶带残留,只发生在最上层,可以擦掉。(背面磨薄制程中,胶带粘表面,SINOMOS 无此制程)
成因 :透明胶状物


Foreign contamination 外来脏污
外观 :不规则状,非透明物,一般呈现条状。
成因 :晶片后续操作中引入,多数在可以清洗掉


corrosion 腐蚀
外观 : Metal Line侧边有泡状/多颗泡状衍生物,造成金属凹陷。
成因 :
a、金属蚀刻后的氯(Cl)残留,遇水气后形成盐酸(HCL)而继续腐蚀金属,包括制程异常造成大量氯残留,PR/Polymer残留氯,放置时间太久;
b、其它酸腐蚀(如BPSG中的P遇水气形成磷酸)。


Crack 龟裂
外观 :非正常图形定义线条,如护层龟裂,破裂处金属光泽较强烈(即较亮)
成因 :
a、VIA龟裂可能SOG不均 或护层结构异常
b、护层龟裂 护层应力不协调或外物DAMAGE。


Si fragment 碎晶片
外观 :有棱角,片岩状碎屑。
成因 :晶片破片,叠片以及刮伤等。


contamination 脏污
外观 :不规则状物
成因 :晶片制程中引入(机台异常或人为操作不当),多数清洗不掉


Dis-color 颜色异常
外观 :强光灯或肉眼下可见WAFER表面颜色不均匀,OM下街道颜色不均匀
成因 :Film 厚度不均匀


Damaged (silicon damage)损伤
外观 :圆圈状,水滴状,如出现在Silicon裸露的街道为聚集的水滴状,向街道交叉处聚集。
成因 :制程中Silicon 裸露时,被*水氨**damage


Hillock 凸起
外观 :在金属表面或测边
a、圆形平顶突起
b、尖顶状突起
c、多角形平頂突起。
成因 :金属原子在热循环(Thermal Cycle)中,因热膨胀系数不同而产生的应力之作用而形成的丘状突起。


Nitride haze 氮化硅表面雾状
外观 :发生在Nitride 层,强光灯下可见雾状物,OM下为密集的细小PA (暗区检查较好)。
成因 :SIN反应中固体产物抽离不及,落在WAFER 上。


local defocus 区域聚焦不良
外观 :OM下图形有基本形貌,但不同程度变形
成因 : defocus (机台异常或WAFER 底部不平坦)


mis-alignment 对准不良
外观 :图形偏移,与其他图形重叠 全批/单片重复性缺陷
成因 : Layer to layer mis-alignment 或REWORK 图形残留


Non-uniform 颜色 / 线不均匀
外观 : VIA层有液滴或条状突起
成因 :
a、SOG涂布时湿度控制不良,造成泡沫状或条状突起。
b、洗边时,洗边液IPA (压力流量控制不稳)滴入SOG film上。


over etch 蚀刻过度
外观 : 金属线路变窄
成因 : 金属ETCH时 ,polymer 未保护好侧壁导致金属线ETCH 过多,变形


particle 尘埃
典型PA1: COPA
外观 :
a、多存在于T2位置,呈竖列分布;
b、 簇状分布,颗粒size较小且分布相对集中;
c、metal会被particle顶起,且突起部分呈现metal色泽。
成因 : BPSG process 中产生


典型PA2: M1PAM2PA
外观 :
a、不规则块状金属残留,中央有黑色外来物;泪滴状金属残留;
b、PA 附近MET1下CONTACT / MET2 下VIA 不变形
c、此种defect一般会造成金属桥接或者是线条扭曲。
成因 :MET sputter chamber 中产生或TIW TARGET 产生,造成PHOTO PR 定义不良,导致ETCH RE 和图形变形。


典型PA3: PAPA
外观 :
a、 不会导致金属变形桥接
b、PA较大且于护层中引入,导致PAD 定义时变形,且PA周围有护层残留。
成因 : Passivation process引入的particle.


典型PA4: V1PA
外观 :圆形突起, 一般外围有凹痕
成因 : SOG process引入的particle.


PR burn 光阻烧焦
外观 :PR内缩,黑色残留物,不易去除。
成因 : 高能量过程导致光阻烧焦。


Pits 凹洞
外观 :金屬Pad或是線路上有凹洞,OM 下为非凸起的小黑点。
如Pits 产生于ETCH 前,ETCH 后街道一定有RE,RE通常有顆粒狀核心存在。如Pits 产生于ETCH 后,街道CLEAR。
只在ALSICU 制程中产生。 MET 2 较易发生Pits,如在MET PHOTO有 疑似当层pits ,请务必到ETCH 后再CHECK。如有RE则为Pits,判断是否报废,如无RE ,则非Pits
请注意判断RE所在FILM,及MET 1/ MET2 上是否有同样defect
成因 :在凹洞之中的顆粒狀核心即為Theta Phase (AlOCu )析出 。黄光显影液腐蚀,ACT槽腐蚀,或MET FILM process 温度过低。

polymer 聚合物
外观 : Pad Contact边缘有丝状或颗粒状残留物。
成因 :
a、 电浆蚀刻(Plasma Etching)后作为侧壁保护或未饱和分子体(Unsaturated)形成的高分子聚合物(Polymer)未能去除干净而造成的残留。


Poor coating 光阻涂布不良
外观 : 光阻覆盖不完全,可导致FILM在该处被ETCH掉。
成因 :光阻涂布不良


PR lifting 光阻剥离
外观 : Pattern(线路及其他结构)呈歪曲或移位现象
成因 :由光阻移位所造成的问题其外观与薄膜本身移位不同。光阻移位後,是光阻Pattern重叠,所 以在蚀刻后薄膜的 Pattern交接处,仍在同一平面.


PR remaining 光阻残留
外观 :薄膜上有深咖啡色、褐色或黑色的脏污残留;许多微小颗粒呈脉状网络分布。
成因 :PR 去除不良


Powder 粉末
外观 : OM 下 颗粒状密集 PA, SIZE较小
成因 :CVD机台副产物
Residue (ETCH) 蚀刻残留
外观 : 非正常图形的FILM图形。
成因 :
a、蚀刻时终结点(etching point)侦测错误或提早捉到;
b、蚀刻前有异物或particle覆盖在光阻或薄膜上形成etching mask,阻挡蚀刻的进行。
c、FILM 厚度异常导致ETCH 未净


Residue (PHOTO) 黄光光阻残留
外观 : 不规则块状、条状薄膜残留,边缘平缓,呈现液体流动状。
成因 :
a、黄光制程中有particle掉落在晶片表面,阻挡曝光的进行;
b、 显影不良造成pattern未显开。


repeating defect 重复性缺陷
外观 : 在不同SHOT 的相同位置重复发生。
成因 :光罩粘污


roughness 粗糙
典型RF 1 :OXRF
外观 :切割道或Chip内有黑点状或者是絮状残留,metal gate较易出现此类defect。严重时,强光灯下雾状。
成因 :ETCH 导致

典型RF 2 :M1/M2 RF
外观 :金属表面有严重,凸凹不平滑现象经由护层的散射,使金属呈变色现象。
成因 :金属溅镀过程中温度越高,粗糙程度越高,而变色现象系由于光线经由金属粗糙化表面散射而使颜色变得更深。


scratch 刮伤
典型SC1:MET film SC
外观 :
a、金属FILM有损伤,刮伤中有金属拉伸现象;
b、刮伤区域较为干净,不会产生很多碎屑,刮伤大块金属堆积物ETCH后有RE。
c、注意区分Met-1和Met-2.
成因 :人为不规范操作,机台异常 ,叠片,斜插,OM 操作不当。

典型SC2: 显影后ETCH前 SC
外观 :
a、FILM无损伤,或损伤很轻(光阻厚)
b、ETCH后检查刮伤区域图形散乱,但在同一平面上
c、注意区分Met-1和Met-2.
成因 :人为不规范操作,机台异常 ,叠片,斜插,OM 操作不当。


典型SC3:METETCH后 SC
外观 :
a、金属线条有损伤,刮伤边缘有金属被带出;
b、 刮伤区域较为干净,不会产生很多碎屑。
c、请注意区分MET1 MET2
成因 :人为不规范操作,机台异常 ,叠片,斜插,OM 操作不当。


典型SC4:护层 SC
外观 :
a、 3PSG的刮痕一般呈现细沙状,有较多细小颗粒被带出来;
b、 PE-SIN的刮伤一般有应力的表现,且相对较为干净。
(请先确定刮伤是在最表层金属上的层次)
成因 :人为不规范操作,机台异常 ,叠片,斜插,OM 操作不当。


Si precipitate 硅析出
外观 : 金属表面飞蚊状黑色物析出,金属晶界明显。曾发生ALSI制程,为MET FILM 上较粗糙,且有凸起小黑点,ETCH后有细小残留有金属颜色。
成因 :MET FILM sputter 温度异常,或结构变化。


slip 滑移线
外观 : 偏光镜下可见,规则排列直线。OM强光灯下均不可见。
成因 :晶格结构变化,高温制程或EPI生长易产生。


under develop 显影不良
外观 : PR定义图形,显影后周围有旋涡状彩纹。
成因 :显影不良造成光阻不规则残留,ETCH后可导致FILM异常。


water spot 水痕
外观 : OM 下液滴状透明物体,面积较大在强光灯下为雾状。
成因 :CLEAN 或酸槽水槽旋干不良。

